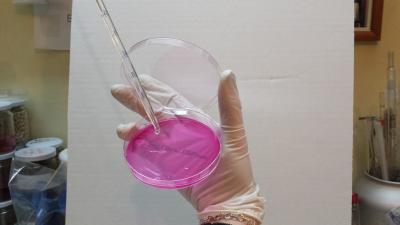

Biotecnología en Valencia
En Edypro hemos trabajado con la biotecnología en Valencia para poder ofrecer un servicio de crecimiento por cultivos de calidad y sin residuos.
Mediante nuestros productos en biotecnología diseñamos un conjunto de soluciones biotecnológicas para el crecimiento empleando siempre técnicas adecuadas para los cultivos. Estudiamos cada caso en concreto y ofrecemos siempre soluciones específicas y de calidad.
EDYPRO, como empresa de futuro en la biotecnología en la agricultura, trabaja respetando el medio ambiente. Los fertilizantes biotecnológicos se elaboran a partir de elementos minerales puros, evitan la pérdida de nutrientes y aportan los minerales esenciales, preservando así la contaminación del suelo de cultivo y de los acuíferos; colaborando, de este modo, a desarrollar una agricultura sostenible con el medio ambiente.
Contacto para Biotecnología en Valencia
Pinchando aquí accedes a nuestro formulario de contacto dónde podrás preguntarnos cualquier tipo de duda sobre nuestros productos y servicios de biotecnología en Valencia. No dudes en consultarnos cualquier cuestión.
Experiencias de biotecnología en la agricultura
-Biotecnología en Valencia para caquis
-Biotecnología en Valencia para aguacate
-Biotecnología en Valencia para el cultivo de arroz
-Biotecnología en Valencia para el cultivo de cítricos
-Biotecnología en Valencia cultivos bajo abrigo
